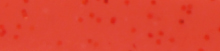

鯛に魅せられたすべてのアングラーに。
ブランド名の由来は、鯛をイメージした美しい“紅色”と獲物に食らいつく鯛の鋭い“牙”。我々を魅了してやまない特別な魚だからこそ、敬意と真剣勝負の駆け引きで鯛との真っ向勝負に挑む。「紅牙」には、そんな想いがこもっている。その領域はタイラバとタイテンヤ。どちらも一尾の鯛に向き合い一対一の勝負に挑むスタイル。「より確実に掛け、そして獲る」そんなアングラーの想いに応えるため、DAIWAは釣りを研究し、具現化する。
鯛に魅せられたすべてのアングラーに勝機と高揚感をもたらすため、「紅牙」はこれからも進み続ける。
紅牙 シリコンネクタイKOHGA SILICONE NECKTIE
紅牙のユニット作りに不可欠なシリコンネクタイ
豊富なカラーバリエーションであらゆるシーンに対応
アイテム | 説明 |
---|---|
STR(ストレート) | セットしやすいオーソドックスな形状。絶妙な張りとコシは実際に使用した多くのアングラーが絶賛。中井一誠テスター監修のオーロラカラー、後迫正憲テスター監修のチョコラメカラー、九州で特に人気のグリーンラメカラーもラインナップ。 |
STC(ストレートカーリー) | ストレートとカーリーを融合させ、両者の「いいトコ取り」をしたモデル。ダブルよりトラブルが少なく、しっかりアピール。泳ぎはストレートのネクタイを中心にカーリーが波打つといったイメージ。 |
中井チューン STRスリム STCスリム |
タイラバ激戦区の和歌山県加太で着実に結果を残すフィールドテスター・中井一誠のシークレットネクタイ。激シブの状況でこそ真価を発揮する。 |
左にスクロール
右にスクロール
カラーバリエーション

■紅牙レッド

■紅牙オレンジ

■間詰(マズメ)チャート

■ゴールドラメ
■才巻オレンジ

■紅牙グリーン

■紅牙ピンク

■オレンジラメ

■レッドラメ

■蜜柑ラメ

■アミラメ

■グローラメ

■ケイムラピンク

■チョコラメ

■グリーンラメ

■ケイムラオレンジラメ

■ゼブラレッド

■ケイムラクリアラメ

■マジカルブラック

■ゼブラグロー

■ゼブラオレンジ

■ケイムラゼブラレッド

■ケイムラゼブラオレンジ

■海藻グリーン
ネクタイ・スカートの交換方法

1.古いネクタイとスカー トを接続パーツαAから外す。

2.紅牙ベイラバーシリコンチューブαを2.5mm程度にカットしてネクタイの先端を通す。

3.シリコンチューブに専用ニードル「紅牙ラバー抜き抜き」の先端を通し、紅牙カットスカートを適量にカットして引っ掛ける。

4.紅牙カットスカートの真ん中にチューブが来るようにニードルを引き抜き、接続パーツαAをチューブに差し込んで固定する。

5.紅牙カットスカートの先端をカットして接続パーツ全体に均等にラバーを配する。

6.あらかじめフックをセットした接続パーツαBと合体させてリーダーに結ぶ。もしくはネクタイ・スカートのついた接続パーツαAにリーダー通して先端に接続パーツαBを結んで合体させる。
発光イメージ

■ケイムラ発光イメージ
※写真はSTCケイムラゼブラオレンジです
ルアースペック比較
アイテム | タイプ | 入数(本) | 素材 |
---|---|---|---|
STR | ストレート | 5 | シリコン |
STC | ストレートカーリー | 3 | シリコン |
中井チューン STRスリム | ストレート | 5 | シリコン |
中井チューン STCスリム | ストレートカーリー | 3 | シリコン |
左にスクロール
右にスクロール
製品スペック
アイテム | タイプ | 素材 | 入数(本) | メーカー希望本体価格(円) | JAN |
---|---|---|---|---|---|
紅牙スペアパーツシリコンネクタイ・紅牙レッドストレートR | ストレート | シリコン | 5 | 480 | 4960652949828 |
紅牙スペアパーツシリコンネクタイ・紅牙オレンジストレートR | ストレート | シリコン | 5 | 480 | 4960652949835 |
紅牙スペアパーツシリコンネクタイ・間詰チャートストレートR | ストレート | シリコン | 5 | 480 | 4960652949842 |
紅牙スペアパーツシリコンネクタイ・ゴールドラメストレートR | ストレート | シリコン | 5 | 480 | 4960652949859 |
紅牙スペアパーツシリコンネクタイ・才巻オレンジストレートR | ストレート | シリコン | 5 | 480 | 4960652949866 |
紅牙スペアパーツシリコンネクタイ・紅牙グリーンストレートR | ストレート | シリコン | 5 | 480 | 4960652949873 |
紅牙スペアパーツシリコンネクタイ・オレンジラメストレートR | ストレート | シリコン | 5 | 480 | 4960652990981 |
紅牙スペアパーツシリコンネクタイ・レッドラメストレートR | ストレート | シリコン | 5 | 480 | 4960652990998 |
紅牙スペアパーツシリコンネクタイ・アミラメストレートR | ストレート | シリコン | 5 | 480 | 4960652991025 |
紅牙スペアパーツシリコンネクタイ・紅牙レッドSTカーリー | ストレートカーリー | シリコン | 3 | 480 | 4960652991032 |
紅牙スペアパーツシリコンネクタイ・紅牙オレンジSTカーリー | ストレートカーリー | シリコン | 3 | 480 | 4960652991049 |
紅牙スペアパーツシリコンネクタイ・紅牙グリーンSTカーリー | ストレートカーリー | シリコン | 3 | 480 | 4960652991070 |
紅牙スペアパーツシリコンネクタイ・グローラメストレート | ストレート | シリコン | 5 | 480 | 4960652998451 |
紅牙スペアパーツシリコンネクタイ・ケイムラピンクSTカーリー | ストレートカーリー | シリコン | 3 | 480 | 4960652998482 |
紅牙スペアパーツシリコンネクタイ・チョコラメ・ストレートR | ストレート | シリコン | 5 | 480 | 4960652058797 |
紅牙スペアパーツシリコンネクタイ・グリーンラメ・ストレートR | ストレート | シリコン | 5 | 480 | 4960652058803 |
紅牙スペアパーツシリコンネクタイ・マジカルブラックストレート | ストレート | シリコン | 5 | 480 | 4960652001847 |
紅牙スペアパーツシリコンネクタイ・マジカルブラック・ストレートカーリー | ストレートカーリー | シリコン | 3 | 480 | 4960652001861 |
紅牙シリコンネクタイ中井チューン・紅牙オレンジ・ストレートスリム | ストレート | シリコン | 5 | 480 | 4960652002004 |
紅牙シリコンネクタイ中井チューン・赤ラメ・ストレートスリム | ストレート | シリコン | 5 | 480 | 4960652002011 |
紅牙シリコンネクタイ中井チューン・オレンジラメ・ストレートスリム | ストレート | シリコン | 5 | 480 | 4960652002035 |
紅牙シリコンネクタイ中井チューン・ゴールドラメ・ストレートスリム | ストレート | シリコン | 5 | 480 | 4960652002042 |
紅牙シリコンネクタイ中井チューン・オレンジゼブラ・ストレートスリム | ストレート | シリコン | 5 | 480 | 4960652002059 |
紅牙シリコンネクタイ中井チューン・レッドゼブラ・ストレートスリム | ストレート | シリコン | 5 | 480 | 4960652002066 |
紅牙シリコンネクタイ中井チューン・ケイムラオレンジ・ストレートスリム | ストレート | シリコン | 5 | 480 | 4960652002073 |
紅牙シリコンネクタイ中井チューン・ゼブラグロー・ストレートスリム | ストレート | シリコン | 5 | 480 | 4960652002080 |
紅牙シリコンネクタイ中井チューン・ケイムラクリア・ストレートスリム | ストレート | シリコン | 5 | 480 | 4960652002103 |
紅牙シリコンネクタイ中井チューン・紅牙オレンジ・ストレートカーリースリム | ストレートカーリー | シリコン | 3 | 480 | 4960652002110 |
紅牙シリコンネクタイ中井チューン・赤ラメ・ストレートカーリースリム | ストレートカーリー | シリコン | 3 | 480 | 4960652002127 |
紅牙シリコンネクタイ中井チューン・オレンジラメ・ストレートカーリースリム | ストレートカーリー | シリコン | 3 | 480 | 4960652002134 |
紅牙シリコンネクタイ中井チューン・ゴールドラメ・ストレートカーリースリム | ストレートカーリー | シリコン | 3 | 480 | 4960652002141 |
紅牙シリコンネクタイ中井チューン・ケイムラオレンジ・ストレートカーリースリム | ストレートカーリー | シリコン | 3 | 480 | 4960652002172 |
紅牙シリコンネクタイ中井チューン・ケイムラクリア・ストレートカーリースリム | ストレートカーリー | シリコン | 3 | 480 | 4960652002202 |
紅牙スペアパーツシリコンネクタイ・オレンジゼブラ・ストレートカーリー | ストレートカーリー | シリコン | 3 | 480 | 4960652103923 |
紅牙スペアパーツシリコンネクタイ・レッドゼブラ・ストレートカーリー | ストレートカーリー | シリコン | 3 | 480 | 4960652103930 |
紅牙スペアパーツシリコンネクタイ・ケイムラオレンジラメ・ストレートカーリー | ストレートカーリー | シリコン | 3 | 480 | 4960652103961 |
紅牙スペアパーツシリコンネクタイ・ケイムラオレンジラメ・ストレート | ストレート | シリコン | 5 | 480 | 4960652103978 |
紅牙スペアパーツシリコンネクタイ・オレンジゼブラ・ストレート | ストレート | シリコン | 5 | 480 | 4960652103985 |
紅牙スペアパーツシリコンネクタイ・レッドゼブラ・ストレート | ストレート | シリコン | 5 | 480 | 4960652103992 |
紅牙スペアパーツシリコンネクタイ・ゼブラグロー・ストレート | ストレート | シリコン | 5 | 480 | 4960652104005 |
紅牙シリコンネクタイ中井チューン・マジカルブラック・ストレートスリム | ストレート | シリコン | 5 | 480 | 4960652286435 |
紅牙シリコンネクタイ中井チューン・グリーンラメ・ストレートスリム | ストレート | シリコン | 5 | 480 | 4960652286442 |
紅牙シリコンネクタイ中井チューン・紅牙グリーン・ストレートスリム | ストレート | シリコン | 5 | 480 | 4960652286459 |
紅牙シリコンネクタイ中井チューン・マズメチャート・ストレートスリム | ストレート | シリコン | 5 | 480 | 4960652286466 |
紅牙シリコンネクタイ中井チューン・紅牙ピンクストレートスリム | ストレート | シリコン | 5 | 480 | 4960652286473 |
紅牙シリコンネクタイ中井チューン・マジカルブラック・ストレートカーリースリム | ストレートカーリー | シリコン | 3 | 480 | 4960652286480 |
紅牙シリコンネクタイ中井チューン・グリーンラメ・ストレートカーリースリム | ストレートカーリー | シリコン | 3 | 480 | 4960652286497 |
紅牙シリコンネクタイ中井チューン・マズメチャート・ストレートカーリースリム | ストレートカーリー | シリコン | 3 | 480 | 4960652286510 |
紅牙シリコンネクタイ中井チューン・紅牙ピンクストレートカーリースリム | ストレートカーリー | シリコン | 3 | 480 | 4960652286527 |
紅牙シリコンネクタイ中井チューン・ゼブラオレンジ・ストレートカーリースリム | ストレートカーリー | シリコン | 3 | 480 | 4960652286534 |
紅牙シリコンネクタイ中井チューン・ゼブラレッド・ストレートカーリースリム | ストレートカーリー | シリコン | 3 | 480 | 4960652286541 |
紅牙シリコンネクタイ中井チューン・ゼブラグロー・ストレートカーリースリム | ストレートカーリー | シリコン | 3 | 480 | 4960652286558 |
紅牙シリコンネクタイ中井チューン・チョコラメ・ストレートカーリースリム | ストレートカーリー | シリコン | 3 | 480 | 4960652286930 |
紅牙シリコンネクタイ中井チューン・ケイムラゼブラレッド・ストレートスリム | ストレート | シリコン | 5 | 480 | 4550133059421 |
紅牙シリコンネクタイ中井チューン・海藻グリーン・ストレートスリム | ストレート | シリコン | 5 | 480 | 4550133059445 |
紅牙シリコンネクタイ中井チューン・蜜柑ラメ・ストレートスリム | ストレート | シリコン | 5 | 480 | 4550133059452 |
紅牙シリコンネクタイ中井チューン・ケイムラゼブラレッド・ストレートカーリースリム | ストレートカーリー | シリコン | 3 | 480 | 4550133059476 |
紅牙シリコンネクタイ中井チューン・ケイムラゼブラオレンジストレートカーリースリム | ストレートカーリー | シリコン | 3 | 480 | 4550133059483 |
紅牙シリコンネクタイ中井チューン・海藻グリーン・ストレートカーリースリム | ストレートカーリー | シリコン | 3 | 480 | 4550133059490 |
紅牙シリコンネクタイ中井チューン・蜜柑ラメ・ストレートカーリースリム | ストレートカーリー | シリコン | 3 | 480 | 4550133059506 |
紅牙シリコンネクタイ中井チューン・アミラメ・ストレートカーリースリム | ストレートカーリー | シリコン | 3 | 480 | 4550133059513 |
- メーカー希望本体価格は税抜表記です。
左にスクロール
右にスクロール
※塗装の上塗りは、変質や不具合を起こす場合があります。あらかじめご了承ください。